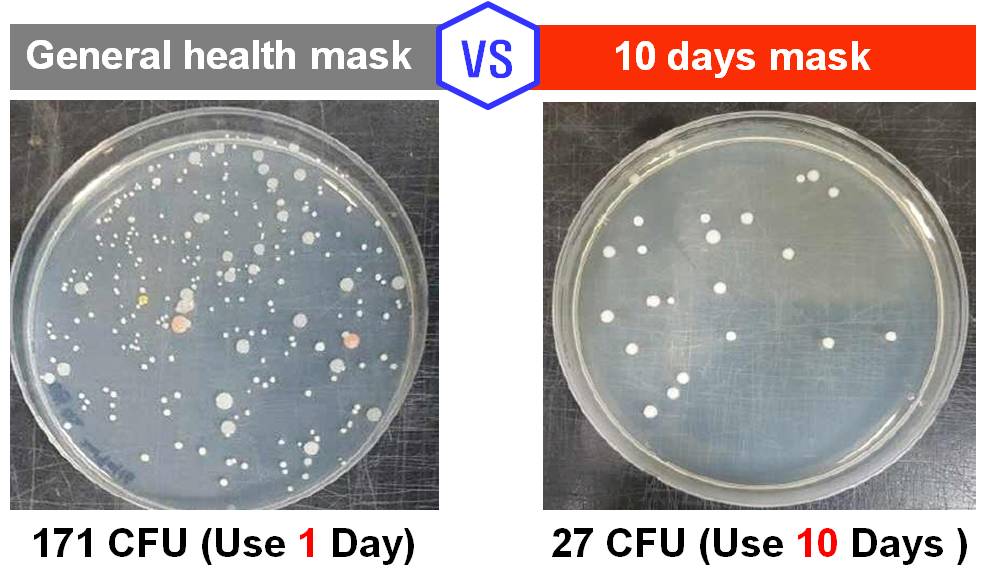
Antimicrobial MASK

- PID
- 3305821
KF94 Type 10 Days Mask
Request For Quotation
Wearing 10days mask reduces the potential for infection by consistently removing pathogens and virus
- Award
-
- Shipping
-
- Lead Time14 ~ 40days
- Modes of Transport FOB
- Products Shipped From Busan,Incheon
- Payment
-
140+ Global Payments, trusted and secure payment provided by PayVerse.
Learn More
- Quantity
- MOQ : 10,000 Pieces
Detailed Description
Certification & Registration

Keyword
Product Data
Other products of this company